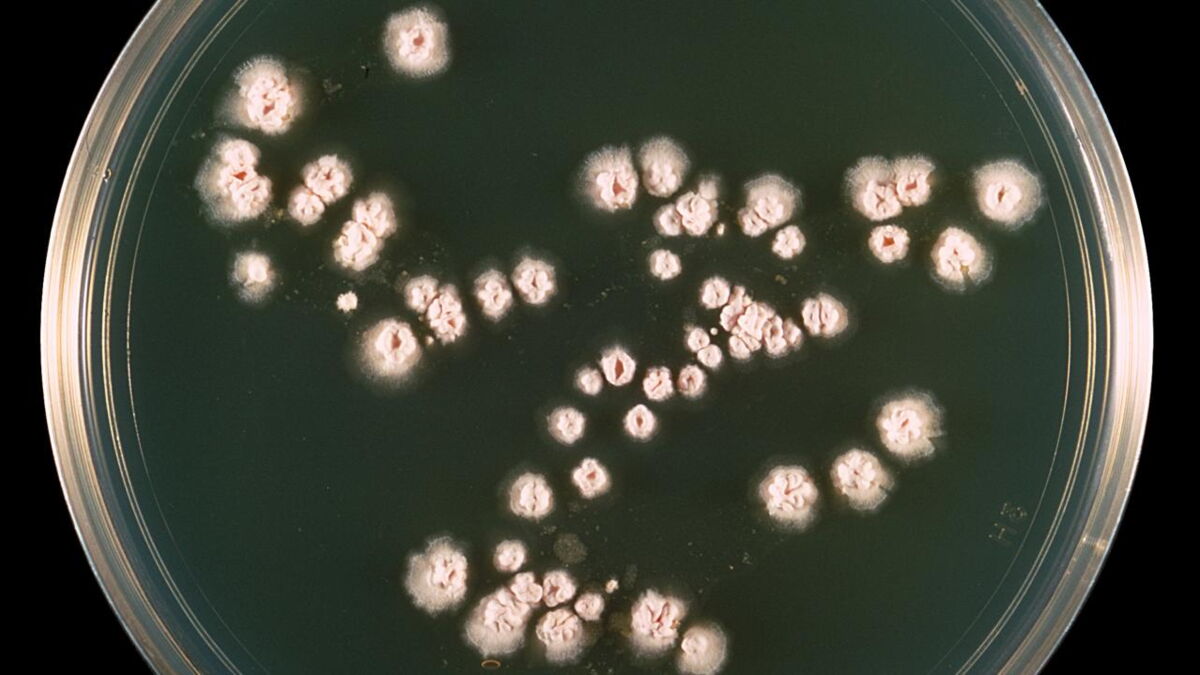

Handschuhfach-Lichtschalter 9351021000 - PP Baugruppe Autoersatzteil
Sehr beliebt
lieferbar - in 1-2 Werktagen bei dir
10 €
inkl. MwSt. zzgl.
Versandkosten
Artikelbeschreibung